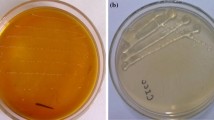

Abstract
The fungus Chaetomium gracile is used for production of dextranase and removal of dextran during sugar manufacturing process, however, the productivity of dextranase is low. In this study, we investigated the influence of carbon source on dextranase production using dextrans of different sizes. Culturing C. gracile in medium containing crude dextran and use of high molecular weight of dextrans resulted in the higher yield of dextranase production (80.5 ± 4.0 U ml−1). Cells incubated in medium containing glucose as sole carbon source exhibited a high growth rate but did not produce dextranase. Based on these findings, fed-batch and two-step fermentation strategies were employed to further increase the yield of dextranase with production of 159.5 and 187.0 U ml−1, respectively.
Similar content being viewed by others
Avoid common mistakes on your manuscript.
Introduction
Dextran is a long carbohydrate polymer formed from α-1,6-glucosidic linkages between sucrose units, and its synthesis is catalysed by a dextransucrase enzyme (Eggleston et al. 2011). During sugar processing, dextransucrase produced by Leuconostoc mesenteroides catalyses the conversion of sucrose to dextran, which consumes sucrose (Purushe et al. 2012). The presence of dextran in sugarcane juice enhances the viscosity which affects filtration, clarification and crystal formation, thereby reducing the quality of the resulting sugar (Zohra et al. 2013). Although different methods such as ultrafiltration, dialysis and reverse osmosis can be used to remove dextran from sugarcane juice, these methods are too expensive and inefficient (Xu et al. 2004). The most applicable method currently employed involves hydrolysis with enzymes (Bhatia et al. 2010), and 6-α-d-glucan-6-glucanohydrolase (dextranase) is used to hydrolyse high molecular weight dextrans (Bashari et al. 2013).
Dextran-degrading enzymes characterized to date exhibit differences in activity and substrate specificity. For example, dextranase from Arthrobacter globiformis hydrolyses dextran and pullulan, whereas dextranase from Thermo anaerobacter failed to hydrolyse pullulan (Finnegan et al. 2004). Dextranase activity is dependent on pH, temperature, incubation time, substrate concentration, and the type and concentration of enzyme used (Eggleston and Monge 2005). During sugar processing, syrup is subjected to high temperatures and the pH may fluctuate, and dextranases that are stable under these conditions are needed. Dextranases isolated from fungi, bacteria and engineered strains have been described, but their use in the sugar industry has not been fully explored due to difficulties in producing them in sufficient quantities, as well as outstanding safety disputes (Kang et al. 2009; Jiménez 2009). Dextranase from Chaetomium gracile is considered safe for use in food, remains stable at 85 °C and between pH 3–7, and is used in the sugar industry (Eggleston et al. 2006). However, dextranase productivity from C. gracile is low and could be improved. In the present study, we investigated different molecular weight (mw) of dextrans as carbon sources, and assessed their influence on dextranase production, and efficient fed-batch and two-step fermentation strategies were developed based on the results.
Materials and Methods
Materials
Dextran standard (70 kDa) was purchased from a commercial supplier (Sigma-Aldrich, St. Louis, MO, USA). Crude dextran was supplied by Shandong Jinyang Biological Pharmaceutical Co. Ltd., (China). Chaetomium gracile (CGMCC3.3783) was obtained from the China General Microbiological Culture Collection (CGMCC, Beijing, China).
Medium and Culture Conditions
Dextranase production was carried out in medium containing 10 g yeast extract, 2.5 g K2HPO4, and 2.5 g MgSO4·7H2O per L, and pH was adjusted to 5.5, as previously described, with modifications (Yoshino et al. 1995). During fermentation, the carbon source and concentrations were as specified in the fermentation section below.
A 3 % pre-inoculum was used to inoculate 25 ml of culture medium in a 250 ml Erlenmeyer flask, and fermentation was carried out as described below. Production of dextranase was monitored during fermentation at 28°C with shaking at 200 rpm between 0–96 h. Cells were harvested by centrifugation (10,000×g, 10 min, 4 °C), and supernatants and pellets were used for the determination of dextranase activity and dry cell weight (DCW), respectively, as previously described with modifications (Cai et al. 2014).
Fermentation
To investigate the effect of dextrans of different sizes on the production of dextranase, dextrans with a mw of 20, 40, 70, 500 and 2000 kDa were used as a carbon source. Dextranase activity was assayed as described in the analytical methods section below. The optimal dextran size from three duplicate experiments was used as carbon source in subsequent fermentations.
In the fed-batch fermentation process, cells were initially incubated in medium containing 1 % glucose as the sole carbon source, and supplemented with dextran to a final concentration of 0.5–2 %. During the fermentation process, dextranase activity and DCW were measured between 0 and 32 h in 4 h increments.
In the two-step fermentation process, incubation was initially performed in medium containing 1 % glucose as the sole carbon source, followed by incubation for a further 0–32 h before harvesting by centrifugation. Cell pellets were washed twice with sterilized water and transferred into fresh medium and further incubated for 96 h.
Analytical Methods
Dextranase Assay
Dextranase activity was determined by measuring the reducing sugar liberated from the action of dextranase on its dextran substrate. The cell free filtrate (1 ml) was incubated with 4 ml of substrate (3 % dextran, T70) in 0.02 M acetate buffer (pH 5.0) and incubated at 28 °C for 30 min. Dextranase activity was measured using the 3,5-dinitrosalicylic acid method (Wu et al. 2011). One unit of dextranase was defined as the amount of enzyme required to produce 1 μM of reducing sugar per min.
DCW Determination
Triplicate DCW determinations (25 ml per sample) were carried out after drying cells overnight at 105 °C as previously described (Basan et al. 2007).
Results
Dextranase Activity of C. gracile Cultured in Dextran Medium
To evaluate dextranase activity of C. gracile cultured in medium containing dextrans of different mw, 1 % dextran was added. Upon addition of dextrans from 20 to 500 kDa, dextranase activity was increased from 9.85 ± 0.65 to 32.5 ± 2.55 U ml−1 (Fig. 1). However, when the dextran mw was further increased to 2000 kDa, the dextranase activity decreased to 8.65 ± 0.50 U ml−1. This may be because high mw dextrans are resistant to degradation by microorganisms, as previously suggested (Erhardt and Jordening 2007). Interestingly, crude dextran (20–2000 kDa, 90 % with a mw ~1000 kDa) stimulated dextranase activity to reach 80.5 ± 4.0 U ml−1, higher than that achieved by addition of 2000 kDa dextran alone (Fig. 1). Analysis of DCW revealed a similar trend to dextranase production, suggesting crude dextran containing dextrans of different mw increases both cell growth and enzyme production (Fig. 1).
Dextranase production and dry cell weight (DCW) following fermentation of C. gracile supplemented with different mw dextrans. Open columns represent dextranase production. Lines in open squares represent changes in DCW. T20, T40, T70, T500 and T2000 refer to dextrans with a mw of 20, 40, 70, 500 and 2000 kDa, respectively
Growth of C. gracile Cultured on Glucose and Dextran
Increased production of enzymes can metabolically affected the cells and inhibit their growth (van Rensburg et al. 2012), and increasing biomass may therefore be favourable to compensate. In this study, C. gracile was cultured in medium containing glucose or dextran as the sole carbon source, and growth on glucose resulted in a DCW of 2.54 g l−1 after incubation for 16 h, with a maximum DCW of 7.76 g l−1 at 40 h (Fig. 2). In contrast, growth on dextran reached 1.16 g l−1 after 16 h and a maximum of 6.46 g l−1 at 56 h (Fig. 2).
Dextranase production and DCW following fermentation of C. gracile on glucose and crude dextran as a carbon source. Open and grey columns represent DCW of C. gracile grown on crude dextran and glucose as carbon source, respectively. Lines in triangles and squares represent dextranase production in C. gracile cultured on crude dextran and glucose, respectively
Only a small amount of dextranase was produced from cells grown on dextran during the first 24 h, but production gradually increased upon further incubation and reached a maximum of 80.5 ± 4.0 U ml−1 at 72 h, whereas dextranase was not detected in cells grown on glucose (Fig. 2). These results suggest an initial rapid growth phase, and indicate that sufficient biomass was needed to produce dextranase, consistent with production of other inducible enzymes (Sommer et al. 2011).
Optimization of Fed-batch Fermentation
To increase biomass and maximize dextranase production, a fed-batch fermentation strategy was tested. First, the optimal time was investigated in media containing 1 % glucose, and 1 % dextran was added every 4 h between 0 and 36 h. As shown in Fig. 3a, dextranase production was significantly increased and reached a maximum of 159.5 ± 7.5 U ml−1 when the supplementation time was 20 h. Followed with a slightly decrease in dextranase production during 24–36 h. The optimal time of 20 h was thus used in subsequent fermentations.
The optimal concentration of dextran was also investigated in medium containing glucose. As shown in Fig. 3b, following addition of dextran, the production of dextranase increased significantly and peaked at 64 h. Compared with a supplementation of 0.5 % dextran, maximum dextranase production was increased by 31.4 % and reached 159.5 ± 7.5 U ml−1 upon addition of 1.0 % dextran. However, when supplementation was further increased to 2 %, dextranase production decreased to 129.5 ± 5.0 U ml−1, possibly due to higher osmotic pressure that may inhibit dextranase secretion.
A fed-batch strategy involving addition of 1 % dextran at 20 h was thus optimal, and shortening the fermentation time from 72 to 64 h was also beneficial. Overall, dextranase production was 97.3 % higher than in medium containing dextran as the sole carbon source.
Evaluation of a Two-step Fermentation Strategy
We also evaluated a two-step fermentation strategy, which has proved beneficial for both cell growth and productivity in numerous microorganisms (Long et al. 2008; Jung and Lee 2011). In this study, cell pellets were incubated in glucose medium for 20 h (the optimal time determined in earlier experiments), transferred into fresh medium containing 1 % dextran (the optimal time determined in earlier experiments), and further incubated to 96 h. Cell growth and dextranase production were compared with the fed-batch strategy, and cells incubated in dextran medium were used as controls (Fig. 4).
Evaluation of fed-batch and two-step fermentation strategies. Lines in reversed triangles, triangles and circles represent dextranase production in the control fermentation, fed-batch and two-step fermentation strategies, respectively. White, light grey and dark grey columns represent the DCW in the control fermentation, fed-batch and two-step fermentation strategies, respectively
The results showed that dextranase production with a two-step incubation strategy was lower than observed in the fed-batch incubation and controls between 20 and 32 h. However, dextranase production increased rapidly after 32 h and peaked at 187.0 ± 9.5 U ml−1 at 64 h, which was higher than controls and the fed-batch strategy. DCW exhibited a similar trend to dextranase production, and reached 8.42 g/l (Fig. 4). Batch fermentation resulted in a 132 % increase in dextranase production compared with controls.
Discussion
The importance of dextranases in the sugar industry for alleviating the viscosity of syrups and cleaning blocked machines has been discussed and much effort has focused on isolating dextran-degrading organisms that produce large quantities of thermostable dextranases from regular and harsh environments (Zohra et al. 2013). In this study, a high concentration of dextranase was produced by C. gracile grown on crude dextran. Fed-batch and two-step fermentation strategies further improved dextran production, to 159.5 ± 7.5 and 187.0 ± 9.5 U ml−1, respectively.
In previous studies, the average dextran size reported to improve enzyme production varied under different fermentation conditions. For example, a 70 kDa dextran was reported by using Penicillium aculeatum, while that reported for Penicillium funiculosum was 258 and Thermoanaerobacter species were 260 and ~2000 kDa, respectively (Gan et al. 2014). In the present study, crude dextran (20–2000 kDa) increased dextran production in C. gracile to 80.5 ± 4.0 U ml−1 (Fig. 1). Dextran is presumed to serves as both a carbon source and inducer for the production of dextranase, and the ability to act as an inducer is dependent on physical parameters such as mw, concentration and degree of branching (Khalikova et al. 2005). For example, low mw dextrans may serve as an inducer rather than a carbon source, and a high concentration of low mw dextran inhibited the secretion of dextranase (Khalikova et al. 2005; Daisuke et al. 1971). Regular mw of dextran in fermentation liquor may result in a high osmotic pressure and deficiency as an inducer; whereas crude dextran contains different mw of dextran and could benefit both cell growth and enzyme production, as indicated by the results of this study (Fig. 1).
During cultivation of C. gracile, rapid cell growth occurred with glucose as the substrate, but dextranase was not produced in these conditions. In contrast, cell growth was lower with dextran as carbon source, and dextranase was produced by these slow growing cells. Provision of the appropriate concentration of glucose and dextran therefore favours dextranase production, as previously observed (Koenig and Day 1989; Kim and Kim 2010). In this study, a fed-batch strategy involving supplementation of 1 % dextran to the medium at 20 h increased dextranase production, consistent with the addition 1 % dextran T20 that increased production of dextranase in Catenovulum sp. (Cai et al. 2014). Shortening the fed-batch fermentation time from 72 to 64 h also improved the dextranase yield. A two-step fermentation strategy increased dextranase production even further with a shorter fermentation time of 64 h (Fig. 4). These results indicated that both fed-batch and two-step fermentation strategies resulted in efficient production of dextranase in C. gracile.
Enzymes are now preferred over chemical catalysts in numerous industries, but they must be able to retain activity in potentially harsh industrial processing conditions. The stability of dextranase enzymes should be further improved to facilitate their use in industrial applications, and this can be achieved through directed evolution or random mutagenesis, which that have served well for other biocatalysts (Bloom et al. 2005; Johannes and Zhao 2006). Protein engineering of the catalytic site and substrate-binding pockets could also be used to improve dextranase properties. Indeed, replacing some amino acids has already been used to modify the catalytic site and thermostability of these enzymes to improve their properties (Hild et al. 2007). Therefore, efficacy of C. gracile could be improved using UV mutagenesis, genome shuffling or other approaches aimed at altering gene expression to further increase dextranase production and improve the properties of these enzymes for industrial applications.
References
Basan, H., M. Gumusderelioglu, and M.T. Orbey. 2007. Release characteristics of salmon calcitonin from dextran hydrogels for colon-specific delivery. European Journal of Pharmaceutics and Biopharmaceutics 65(1): 39–46. doi:10.1016/j.ejpb.2006.07.008.
Bashari, M., F. Tounkara, M.H. Abdelhai, C. Lagnika, X.M. Xu, and Z.Y. Jin. 2013. Impact of dextranase on sugar manufacturing and its kinetic on the molecular weights of remaining dextran. Sugar Tech 15(1): 84–93. doi:10.1007/s12355-012-0195-4.
Bhatia, S., G. Bhakri, M. Arora, S.K. Uppal, and S.K. Batta. 2010. Dextranase production from Paecilomyces lilacinus and its application for dextran removal from sugarcane juice. Sugar Tech 12(2): 133–138.
Bloom, J.D., M.M. Meyer, P. Meinhold, C.R. Otey, D. MacMillan, and F.H. Arnold. 2005. Evolving strategies for enzyme engineering. Current Opinion in Structural Biology 15(4): 447–452. doi:10.1016/j.sbi.2005.06.004.
Cai, R.H., M.S. Lu, Y.W. Fang, Y.L. Jiao, Q. Zhu, Z.P. Liu, and S.J. Wang. 2014. Screening, production, and characterization of dextranase from Catenovulum sp. Annals of Microbiology 64(1): 147–155. doi:10.1007/s13213-013-0644-7.
Daisuke, T., H. Nobutsugu, H. Tsuneyo, and F. Juichiro. 1971. Studies on mold dextranases. Agricultural and Biological Chemistry 35(11): 1727–1732.
Eggleston, G., and A. Monge. 2005. Optimization of sugarcane factory application of commercial dextranases. Process Biochemistry 40(5): 1881–1894. doi:10.1016/j.procbio.2004.06.025.
Eggleston, G., A. Monge, B. Montes, and D. Stewart. 2006. Factory trials to optimize the application of dextranase in raw sugar manufacture: part I. International Sugar Journal 108(1293): 529–537.
Eggleston, G., G. Cote, and C. Santee. 2011. New insights on the hard-to-boil massecuite phenomenon in raw sugar manufacture. Food Chemistry 126(1): 21–30. doi:10.1016/j.foodchem.2010.10.038.
Erhardt, F.A., and H.J. Jordening. 2007. Immobilization of dextranase from Chaetomium erraticum. Journal of Biotechnology 131(4): 440–447. doi:10.1016/j.jbiotec.2007.07.946.
Finnegan, P.M., S.M. Brumbley, M.G. O’Shea, K.M.H. Nevalainen, and P.L. Bergquist. 2004. Paenibacillus isolates possess diverse dextran-degrading enzymes. Journal of Applied Microbiology 97(3): 477–485. doi:10.1111/j.1365-2672.2004.02325.x.
Gan, W., H. Zhang, Y. Zhang, and X. Hu. 2014. Biosynthesis of oligodextrans with different Mw by synergistic catalysis of dextransucrase and dextranase. Carbohydrate Polymers 112: 387–395. doi:10.1016/j.carbpol.2014.06.018.
Hild, E., S.M. Brumbley, M.G. O’Shea, H. Nevalainen, and P.L. Bergquist. 2007. A Paenibacillus sp. dextranase mutant pool with improved thermostability and activity. Applied Microbiology and Biotechnology 75(5): 1071–1078. doi:10.1007/s00253-007-0936-6.
Jiménez, E.R. 2009. Dextranase in sugar industry: a review. Sugar Tech 11(2): 124–134.
Johannes, T.W., and H. Zhao. 2006. Directed evolution of enzymes and biosynthetic pathways. Current Opinion in Microbiology 9(3): 261–267. doi:10.1016/j.mib.2006.03.003.
Jung, Y.K., and S.Y. Lee. 2011. Efficient production of polylactic acid and its copolymers by metabolically engineered Escherichia coli. Journal of Biotechnology 151(1): 94–101. doi:10.1016/j.jbiotec.2010.11.009.
Kang, H.K., J.Y. Park, J.S. Ahn, S.H. Kim, and D. Kim. 2009. Cloning of a gene encoding dextranase from Lipomyces starkeyi and its expression in Pichia pastoris. Journal of Microbiology and Biotechnology 19(2): 172–177. doi:10.4014/Jmb.0802.100.
Khalikova, E., P. Susi, and T. Korpela. 2005. Microbial dextran-hydrolyzing enzymes: fundamentals and applications. Microbiology and Molecular Biology Reviews 69(2): 306–325.
Kim, Y.-M., and D. Kim. 2010. Characterization of novel thermostable dextranase from Thermotoga lettingae TMO. Applied Microbiology and Biotechnology 85(3): 581–587. doi:10.1007/s00253-009-2121-6.
Koenig, D.W., and D.F. Day. 1989. Induction of Lipomyces starkeyi dextranase. Applied and Environmental Microbiology 55(8): 2079–2081.
Long, L., G.C. Du, C. Jian, W. Miao, and S. Jun. 2008. Influence of culture modes on the microbial production of hyaluronic acid by Streptococcus zooepidemicus. Biotechnology and Bioprocess Engineering 13(3): 269–273. doi:10.1007/s12257-007-0193-7.
Purushe, S., D. Prakash, N.N. Nawani, P. Dhakephalkar, and B. Kapadnis. 2012. Biocatalytic potential of an alkalophilic and thermophilic dextranase as a remedial measure for dextran removal during sugar manufacture. Bioresource technology 115: 2–7. doi:10.1016/j.biortech.2012.01.002.
Sommer, C., N. Volk, and M. Pietzsch. 2011. Model based optimization of the fed-batch production of a highly active transglutaminase variant in Escherichia coli. Protein Expression and Purification 77(1): 9–19. doi:10.1016/j.pep.2010.12.005.
van Rensburg, E., R. den Haan, J. Smith, W.H. van Zyl, and J.F. Gorgens. 2012. The metabolic burden of cellulase expression by recombinant Saccharomyces cerevisiae Y294 in aerobic batch culture. Applied Microbiology and Biotechnology 96(1): 197–209. doi:10.1007/s00253-012-4037-9.
Wu, D.T., H.B. Zhang, L.J. Huang, and X.Q. Hu. 2011. Purification and characterization of extracellular dextranase from a novel producer, Hypocrea lixii F1002, and its use in oligodextran production. Process Biochemistry 46(10): 1942–1950. doi:10.1016/j.procbio.2011.06.025.
Xu, Z.K., Q. Yang, R.Q. Kou, J. Wu, and J.Q. Wang. 2004. First results of hemocompatible membranes fabricated from acrylonitrile copolymers containing sugar moieties. Journal of Membrane Science 243(1–2): 195–202. doi:10.1016/j.memsci.2004.06.020.
Yoshino, S., M. Oishi, R. Moriyama, M. Kato, and N. Tsukagoshi. 1995. Two family G xylanase genes from Chaetomium gracile and their expression in Aspergillus nidulans. Current Genetics 29(1): 73–80.
Zohra, R.R., A. Aman, R.R. Zohra, A. Ansari, M. Ghani, and S.A. Qader. 2013. Dextranase: hyper production of dextran degrading enzyme from newly isolated strain of Bacillus licheniformis. Carbohydrate Polymers 92(2): 2149–2153. doi:10.1016/j.carbpol.2012.11.044.
Acknowledgments
This work was supported by the National Natural Science Foundation of China (31460026, 31560027), the Key Fundamental Research Fund of the Education Department of Guangxi Province (ZD2014001), the Key Scientific Research Fund of Guangxi Province (14122004-2), and the Fundamental Research Fund of Guangxi University (XJZ140293).
Author information
Authors and Affiliations
Corresponding author
Ethics declarations
Conflict of interest
The authors declare that they have no conflict of interest.
Human and Animal Rights
This article does not contain any studies with human or animal subjects.
Rights and permissions
About this article
Cite this article
Li, K., Lu, H., Hang, F. et al. Improved Dextranase Production by Chaetomium gracile Through Optimization of Carbon Source and Fermentation Parameters. Sugar Tech 19, 432–437 (2017). https://doi.org/10.1007/s12355-016-0476-4
Received:
Accepted:
Published:
Issue Date:
DOI: https://doi.org/10.1007/s12355-016-0476-4